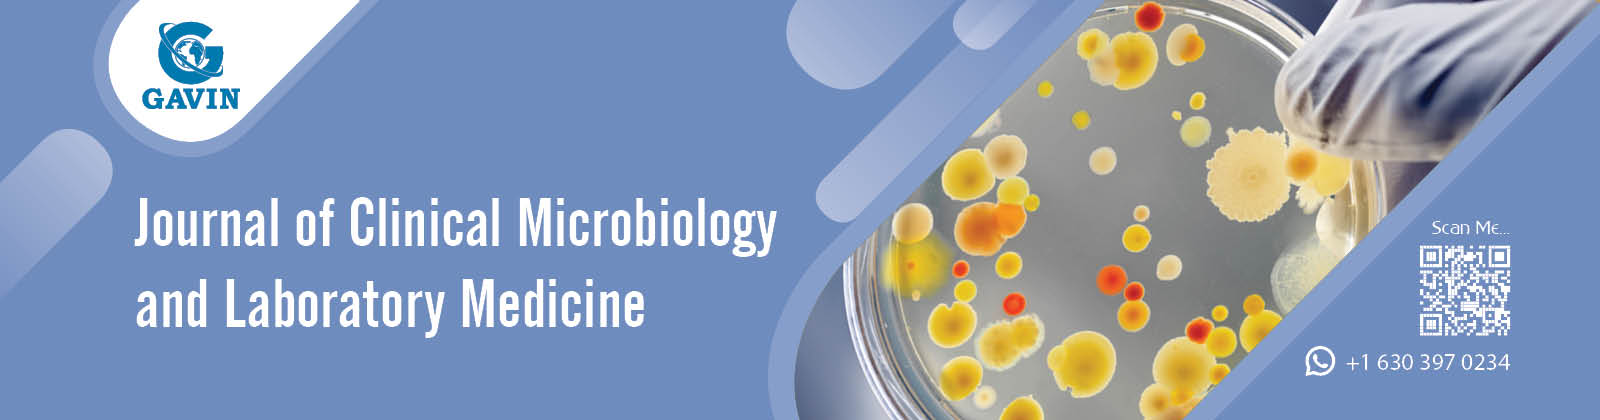
laboratory2

Journal of Clinical Microbiology and Laboratory Medicine

| Abbreviation | J Clin Microbiol Lab Med |
| Publication Type | Peer Reviewed |
| Publishing Model | Open Access |
| DOI Prefix | 10.29011/JCMLM |
| Journal Category | Clinical Microbiology Journals |
About the Journal
Welcome to the "Journal of Clinical Microbiology and Laboratory Medicine" – a peer-reviewed, open-access publication dedicated to advancing knowledge and promoting excellence in the fields of clinical microbiology and laboratory medicine.
Mission
Our mission is to provide a platform for the dissemination of high-quality research and innovative findings that contribute to the understanding and improvement of clinical microbiology and laboratory medicine. We strive to bridge the gap between research and practice, fostering collaboration among scientists, clinicians, and laboratory professionals.
Scope
The journal covers a broad spectrum of topics within clinical microbiology and laboratory medicine, including but not limited to:
- Microbial diagnostics and identification
- Antimicrobial susceptibility testing
- Molecular diagnostics
- Clinical virology
- Mycology and parasitology
- Epidemiology of infectious diseases
- Laboratory quality assurance and accreditation
- Emerging technologies in laboratory medicine
- Point-of-care testing
- Translational research in infectious diseases
- More
Editorial Team
Our esteemed editorial team comprises experts and leaders in the field of clinical microbiology and laboratory medicine. They are committed to maintaining the highest standards of editorial integrity and providing constructive feedback to authors.
Open Access
The "Journal of Clinical Microbiology and Laboratory Medicine" is an open-access journal, ensuring that research findings are freely accessible to a global audience. We believe in the principles of transparency and inclusivity, allowing researchers, clinicians, and the public to benefit from the latest advancements in the field.
Submission Guidelines
Authors interested in submitting their work to the journal can find detailed submission guidelines on our website. We welcome original research articles, reviews, case reports, and other contributions that align with our scope.
Contact Us
For inquiries, collaborations, or any further information, please feel free to contact our editorial office at contact@gavinpublishers.org . We value your feedback and look forward to contributing to the advancement of clinical microbiology and laboratory medicine together.
Thank you for your interest in the "Journal of Clinical Microbiology and Laboratory Medicine."
Editorial Board
Recently Published Articles
False Low HbA1c Levels Under Treatment with Ribavirin
Rein Jan Piso1*, Philipp Walter2, Gottfried Rudofsky 3